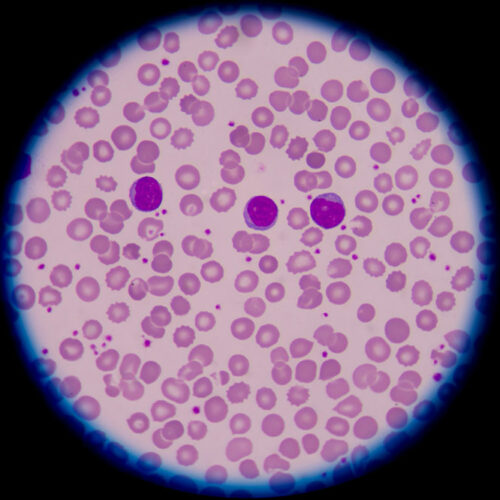
Types of blood disorders you must know about

Decoding certain myths about heart disease
Heart disease can affect people of any age. So, it is essential to understand the underlying conditions and take the requisite steps to improve heart health. However, there are many misconceptions about the triggers of heart diseases and certain myths that need some elucidation before one can seek medical advice.